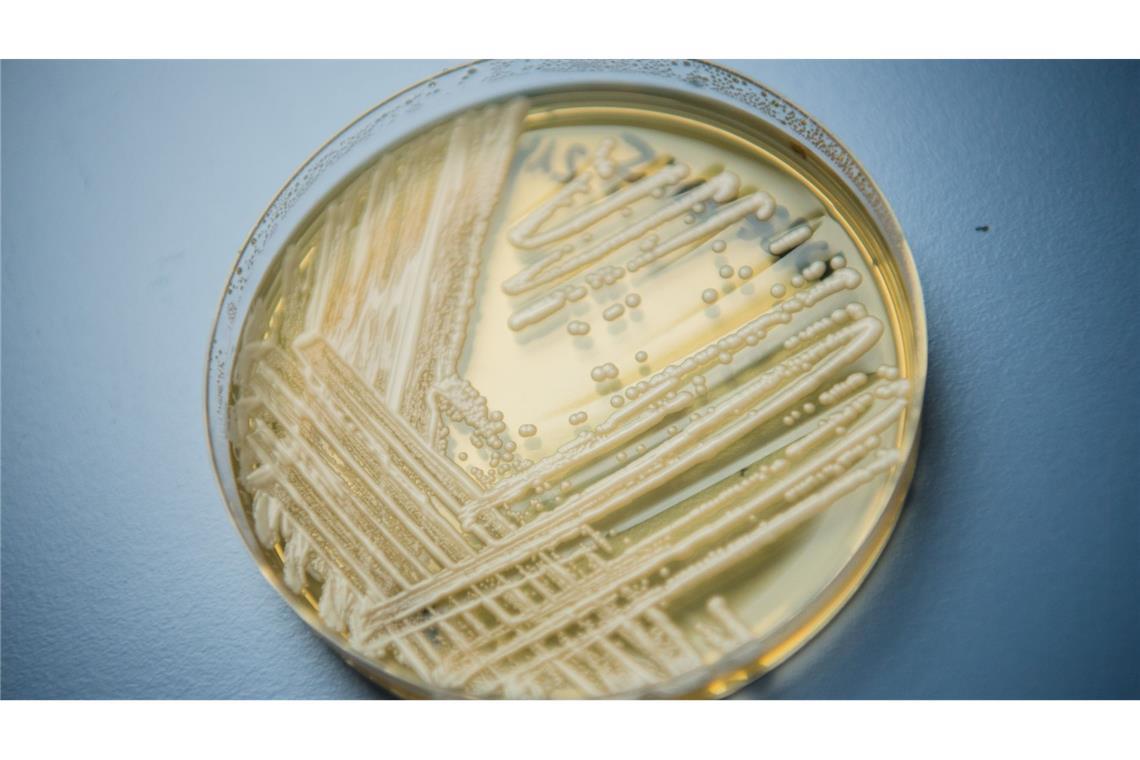
Der Hefepilz Candidozyma auris (früher bekannt als Candida auris).

Erreger
Krankenhaus-Pilz ist weit verbreitet - auch in Deutschland
Der Pilz-Erreger Candidozyma auris kann vor allem für schon kranke Menschen lebensgefährlich sein. Deutschland gehört zu den fünf EU-Ländern mit den meisten gemeldeten Fällen. Was sagen Experten?
© Nicolas Armer/dpa
Der Hefepilz Candidozyma auris (früher bekannt als Candida auris).
Von dpa
Stockholm - Der krankheitserregende Pilz Candidozyma auris verbreitet sich rasch in europäischen Krankenhäusern. Das geht aus einem Bericht des Europäischen Zentrums für die Prävention und die Kontrolle von Krankheiten (ECDC) hervor. Demnach lag Deutschland bei der Anzahl der gemeldeten Fälle zwischen 2013 und 2023 EU-weit auf Platz fünf. Die meisten Fälle wurden in Spanien gemeldet, danach folgten Griechenland, Italien und Rumänien.
Candidozyma auris - früher bekannt als Candida auris - ist ein Hefepilz, der 2009 erstmals in Japan entdeckt wurde. Seitdem hat er sich in mehreren Weltregionen verbreitet, vor allem in Krankenhäusern. Candidozyma auris ist gegen verschiedene Medikamente resistent und kann bei kranken Menschen schwere Infektionen verursachen.
Die Fähigkeit des Pilzes, auf verschiedenen Oberflächen und medizinischen Geräten zu überleben und sich über sogenannte Schmierinfektionen von Mensch zu Mensch zu übertragen, macht es besonders schwer, die Ausbreitung des Erregers zu kontrollieren, teilte das ECDC in seinem Bericht mit. Durch die Luft, wie etwa das Coronavirus, verbreitet sich der Erreger nicht.
Anstieg der gemeldeten Fälle in vergangenen Jahren
Die Studie der Gesundheitsbehörde zeigt einen rapiden Anstieg an gemeldeten Fällen des Befalls mit dem Hefepilz innerhalb der EU und des Europäischen Wirtschaftsraums. Von 2013 bis 2023 wurden in der Region mehr als 4.000 Fälle registriert - 1.346 davon allein im Jahr 2023. Deutschland meldete in dem untersuchten Zeitraum insgesamt 120 Fälle, mit 77 entfiel mehr als die Hälfte auf das Jahr 2023.
Das ECDC schreibt in seinem Bericht, diese Zahlen seien nur "die Spitze des Eisbergs", da es in vielen Ländern keine systematische Erfassung des Befalls mit dem Pilz gebe. Nationale Bemühungen zur Früherkennung, Überwachung und schnellen Umsetzung von Maßnahmen zur Eindämmung der weiteren Ausbreitung von Candidozyma auris könnten die Auswirkungen auf Krankenhauspatienten in Europa abmildern, heißt es in dem Bericht der EU-Behörde.
Experte: Kein Grund zur Sorge in Deutschland
Oliver Kurzai, Leiter des Instituts für Hygiene und Mikrobiologie an der Julius-Maximilians-Universität Würzburg, erläuterte bei einem am Mittwoch dazu abgehaltenen Presse-Briefing des Science Media Centers, Krankenhauspatienten in Deutschland müssten sich trotz der steigenden Fallzahlen keine Sorgen machen. Der Pilz sei in Deutschland eine "Rarität".
"Es macht uns Sorgen aus epidemiologischer Sicht, aber für den einzelnen individuellen Patienten ist die Wahrscheinlichkeit, damit in Kontakt zu kommen, niedrig", so Kurzai.



